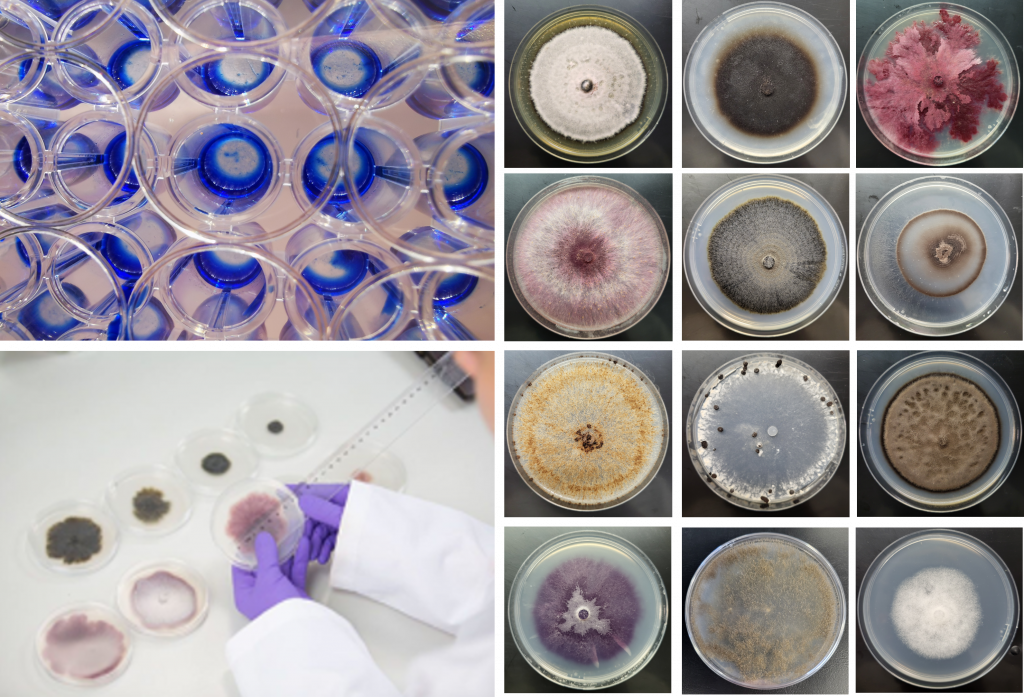
in-vitro-photo-scaled.png

Staphyt’s Phytopathology and Nutrition laboratory
In support of research programmes or upstream and downstream of registration, the Staphyt’s Phytopathology and Plant Nutrition Laboratory has all the equipment and know-how required to test, select and evaluate active substances and formulated conventional and organic products.
Tests under controlled conditions are usually carried out prior to field trials and are complementary to them.
With its extensive experience in crop protection and nutrition, the team can offer you standardised protocols or customized tests to help you to characterise your products.
The laboratory based in France (Martillac, Bordeaux) offers more than 1,200 m2 of infrastructure and increased capacity for trials under controlled conditions (growth chambers), in regulated glasshouse and in tunnel greenhouses (protected conditions).
Our human resources, facilities and equipment
- Multi-disciplinary team of qualified experts
- +800m² plant pathology and plant nutrition laboratory,
- 150 m2 automated greenhouse for the production of plant material needed to carry out trials all year-round,
- 150 m2 automated greenhouse and 50 m2 tunnel dedicated to carry out trials to evaluate bionutrition and biostimulation products,
- 5 growth chambers, 5 incubators and 4 climatic chambers of 30 m² of for carrying out trials under controlled conditions,
- 2 spray booths for precise and homogeneous application of products (adjustable number and type of nozzle, application volume determined according to the crops).
- Measuring equipment (SPAD, greenseeker….), analysis equipment (spectrophotometer; winrhizo) and observation equipment (microscopes, stereomicroscope),
- A molecular biology platform equipped for nucleic acid extraction, PCR, qPCR, etc.

A CRO involved both uptstream and downstream of the regulatory registration process
Monitoring assay – Fungicide resistance

Leveraging Staphyt’s network of experimental stations and local partners, the laboratory has structured access to pathogen samples collected throughout Europe. This broad geographical coverage allows us to collect representative pathogen populations, establish their sensitivity profile distributions to multiple active ingredients, and identify any regional shifts in sensitivity at an early stage.

To ensure rigorous and quantitative monitoring of the sensitivity of crop pathogens and also weed to various active ingredients, we perform some complementary tests: in vitro, in vivo, in planta and also molecular tools used to detect or quantify mutations responsible for pathogen or weed resistance.
First steps of product screening
- Screening of active substances (conventional, biocontrol or SDP plants protection products);
- Determination of the action mode: preventive, curative, research for the activated signalling pathway, etc;
- Determination of the direct effect: inhibition of spore germination, visualization of the elongation tube, radial growth, etc;
- Demonstration of the activation of plant defence pathways by SDP products with molecular tools;
- Phytotoxicity study in planta and selectivity study on seeds
- Product physical and chemical compatibility tests (static and dynamic),
- Study of spray quality according to adjuvants use (retention, spreading/coverage, penetration test),
Evaluation of plant protection products efficacy
- More than 28 diseases (foliar, soil-borne or fungal) and more than fifteen plant species (field crops, perennial crops and vegetables);
- Evaluation of rainfastness activity with adaptable range of rain.
Here are some visual examples of our pathotests. Feel free to contact us for more details: contact@staphyt.com
In vitro tests:
In vivo tests: In planta tests:


Evaluation of fertilizer, biofertilizer, biostimulant and growth regulator products
Evaluating the efficacy and characterizing the mode of action of a nutritional or biostimulation product are crucial steps to validate the claims, securing technical positioning, and guiding development and market launch strategies.
In this context, Staphyt supports its partners in setting up customized trials, while adhering to the FprEN 17700 standard.

Experiments can be deployed at different scales: under controlled conditions (climatic chamber) and under protected conditions (regulated glass greenhouse and tunnel greenhouse)
Each protocol can be adapted according to the product’s positioning, the number of applications, the number and type of assessments.
Staphyt will assist you according to the claim in question:
Tolerance of abiotic stress:
- Determining the effectiveness of products in resisting abiotic stresses (water, salt, cold, …)

Determination of quality traits:
- Observation of morphological and physiological responses (leaf area, leaf and root biomass, height, yields, chlorophyll index, etc.),
- Effect on germination
- Evaluation of the effect on the root architecture (number of forks, tips, root length, root diameter)

Nutrient use efficiency:

- Determination of the partial factor productivity: an agronomic indicator that expresses the yield obtained per unit of an applied input (often nitroge
n), calculated as the ratio between the harvested production and the quantity of input applied, allowing the apparent efficiency of use of this input to be assessed. - Determination of the nutrient export
For all your projects in Plant Nutrition and Plant Protection, our laboratory is your solution!
Contact us at: contact@staphyt.com

